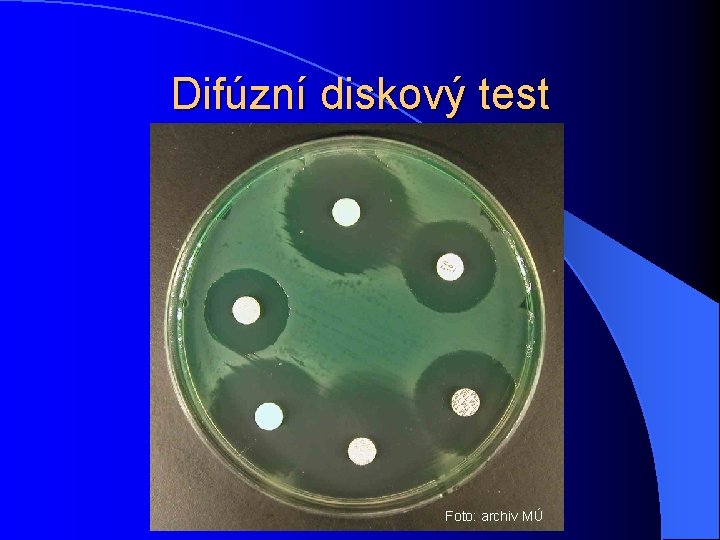
Difúzní diskový test Foto: archiv MÚ

Antimikrobiln ltky Klinick mikrobiologie BZKM 021 p c

Antimikrobiální látky Klinická mikrobiologie – BZKM 021 p + c Týden 4 Ondřej Zahradníček

Možnosti „boje“ s mikroby l Imunizace – využívá přirozených mechanismů makroorganismu l Dekontaminační metody – hrubé fyzikální a chemické vlivy, působení vně organismu l Antimikrobiální látky – jemné, cílené působení uvnitř organismu s cílem maximálního zásahu mikroba a minimálního vlivu na makroorganismus

Ještě dekontaminace, nebo už antimikrobiální látka? l Hranice mezi dekontaminačními metodami a antimikrobiálními látkami je neostrá. l Zpravidla se za dekontaminaci ještě považuje působení na neporušenou kůži. l Aplikace do rány už znamená užití antimikrobiální látky (antiseptika) l Důsledky i legislativní: dekontaminační prostředky schvaluje hlavní hygienik, antimikrobiální látky stejně jako ostatní léky SÚKL

Druhy antimikrobiálních látek l Látky působící celkově: – Antiparazitární látky proti parazitům – Antimykotika proti kvasinkám a vláknitým houbám – Antivirotika proti virům – Antituberkulotika proti mykobakteriím – Antibiotika proti bakteriím (přírodního původu) – Antibakteriální chemoterapeutika také proti bakteriím, ale syntetická V poslední době se stírají rozdíly mezi posledními dvěma l Látky působící lokálně: antiseptika

Působení určitých vlivů na mikroby I l Při působení vlivu jako je p. H má osa působení horní i dolní extrém • Při působení antimikrobiálních látek má logický smysl pouze pravá polovina osy

Působení vlivů na mikroby II l Při dekontaminaci trváme na usmrcení mikrobů (mikrobicidní efekt) l Při užití antimikrobiálních látek můžeme počítat se spoluprací pacientovy imunity, proto obvykle stačí i mikrobistatický (inhibiční) účinek l Toto však neplatí u akutních stavů či imunokompromitovaných pacientů, kde se snažíme o mikrobicidní působení vždy

MIC, MBC, primárně baktericidní a primárně bakteriostatická atb MIC – minimální inhibiční koncentrace je pojem, který se u antibiotik používá pro označení meze růstu (množení) mikroba MBC – minimální baktericidní koncentrace se používá pro mez přežití bakterie. U virů by se použil pojem „minimální virucidní“ a podobně. Primárně baktericidní jsou atb, kde MIC a MBC jsou si téměř rovny Primárně bakteriostatická jsou atb, u kterých se využívá hodnoty nad MIC, ale nikoli nad MBC

Primárně baktericidní a primárně bakteriostatická atb

Mechanismy působení antibiotik l Na buněčnou stěnu (baktericidní) – Betalaktamová antibiotika – Glykopeptidová antibiotika (částečně) l Na cyt. membránu – polypeptidy (baktericidní) l Na nukleovou kyselinu – chinolony (baktericidní) l Na proteosyntézu: aminoglykosidy (baktericidní); makrolidy, tetracykliny, linkosamidy, amfenikoly (bakteriostatické) l Na metabolismus – sulfonamidy, bakteriostatické PRIMÁRNĚ BAKTERIOSTATICKÁ ATB U ZÁVAŽNÝCH AKUTNÍCH STAVŮ NE!

Betalaktamová antibiotika l Působení na buněčnou stěnu l Jsou baktericidní, působí však jen na rostoucí bakterie, které si budují stěnu l Jsou téměř netoxické (lidské buňky stěnu nemají), ale mohou alergizovat l Patří sem: – Peniciliny – Cefalosporiny – Monobaktamy – Karbapenemy

Penicilinová antibiotika l Klasický „Flemingův penicilin“ je stále dobrý např. na angíny. Existuje injekční (G-penicilin) a tabletová (V-penicilin) forma l Oxacilin – na stafylokoky l Ampicilin a amoxicilin – na některé enterobakterie, enterokoky a další mikroby l Další rozšíření spektra: piperacilin, tikarcilin apod. l Peniciliny potencované inhibitory betalaktamáz (viz dále): amoxicilin + kyselina klavulanová, ampicilin + sulbaktam

Inhibitory betalaktamáz – 1 • Působíme-li samotným antibiotikem, je inaktivováno bakteriální betalaktamázou.

Inhibitory betalaktamáz – 2 • Má-li však laktamáza na výběr atraktivnější substrát, zvolí si ho, a antibiotikum pak může nerušeně působit.

Ukázky penicilinů Všechny fotografie antibiotik převzaty z AISLP na intranetu FN USA

Cefalosporiny l Příbuzné penicilinům, přesto nebývají zkřížené alergické reakce, i když je nutná opatrnost. l I. generace: na G+ bakterie, např. cefalexin l II. generace: více na enterobakterie, např. cefuroxim (ZINNAT, ZINACEF) l III. generace: i na některé rezistentní Gbakterie (ceftriaxon, cefotaxim) l IV. generace: cefepim (MAXIPIME), rezervní na velmi rezistentní mikroby

Ukázky cefalosporinů

„Nové betalaktamy“ l Monobaktamy – nejvýznamnějším zástupcem je aztreonam (AZACTAM). Neúčinkují na G+. l Karbapenemy – imipenem (TIENAM) a meropenem (MERONEM) – na pseudomonády a producenty betalaktmáz

Glykopeptidová antibiotika l Působí také na syntézu buněčné stěny, nejsou však příbuzná s betalaktamy. Jsou jen na G+. l Používají se jako rezervní, např. u methicilin rezistentních stafylokoků (MRSA) l Patří sem vankomycin (EDICIN) a méně toxický, ale dražší teikoplanin (TARGOCID)

NN N NN Polypeptidová antibiotika l Působí na cytoplasmatickou membránu l Jsou vysoce toxická: ototoxická, nefrotoxická l Polymyxin B se používá jen lokálně (např. součást ušních kapek Otosporin) l Polymyxin E – kolistin se ve výjimečných případech užívá celkově l Působí i na nerostoucí bakterie l Rezistentní jsou všechny grampozitivní bakterie a všechny protey, providencie, morganelly a serratie

Chinolonová chemoterapeutika I l Působí na nukleové kyseliny (inhibice gyrázy) l Od 2. generace jsou baktericidní l Nepodávat do 15 let (růstové chrupavky) l I. generace (kyselina oxolinová) a II. generace (norfloxacin – NOLICIN) jen pro močové infekce l Hodně používaná III. generace – ofloxacin (TARIVID), ciprofloxacin (CIPLOX), pefloxacin (ABAKTAL) – i pro systémové infekce „

Aminoglykosidy l Působí baktericidně v úvodu proteosyntézy l Jsou ototoxické a nefrotoxické l Synergie s betalaktamy – snížení toxicity l Streptomycin už jen antituberkulotikum. Užívá se gentamicin, netilmicin, amikacin l Neomycin s bacitracinem = framykoin (neomycin je příliš toxický, proto jen lokálně) Už ve starých dílech „Nemocnice na kraji města“ se léčí „gentlemanovýma kouličkama“… vlastně gentamicinovými kuličkami

Ukázky aminoglykosidů

Makrolidy, linkosamidy, tetracykliny, amfenikoly Působí na proteosynézu, avšak nikoli na její počáteční fázi. Všechny jsou bakteriostatické l Makrolidy a linkosamidy jsou vhodné jen pro grampozitivní bakterie (až na výjimky, jako jsou hemofily a některé G- anaeroby) l Tetracykliny a amfenikoly mají široké spektrum l Tetracykliny a amfenikoly patří k starším antibiotikům, dnes se pro toxicitu užívají spíše méně. Naopak makrolidy se dnes až nadužívají. l

Makrolidy (a azalidy) I. generace: erythromycin, v praxi se užívá málo. l II. generace: roxithromycin (RULID); josamycin (WILPRAFEN) a spiramycin se příliš nepoužívají l III. generace: klarithromycin (KLACID), azithromycin (SUMAMED). Azithromycin je vlastně azalid, od ostatních se liší lepším intracelulárním průnikem a dlouhodobým účinkem l

Linkosamidy l Používá se linkomycin (LINCOCIN) a klindamycin (DALACIN C) l Rezervní antibiotika určená zejména pro použití v orotpedii a chirurgii • Velmi dobrý účinek na většinu anaerobů • Výjimkou je Clostridium difficile – riziko pseudomembranosní enterokolitidy

Ukázky makrolidů a linkosamidů

Tetracyklinová antibiotika l Poměrně široké spektrum, ale mohou být sekundární rezistence l Nesmějí se podávat do deseti let (vývoj zubů) l Používají se dnes méně než dříve, ale občas jsou stále nenahraditelné Chloramfenikol (amfenikoly) • Široké spektrum a nepříbuznost s jinými atb • Vynikající průnik do likvoru • Avšak: je výrazně hematotoxický (ovlivnění krvetvorby)

Tetracykliny a amfenikoly – ukázky

Analoga kyseliny listové l Nejběžnější je sulfametoxazol v kombinaci s. pyrimidinovým chemoterapeutikem trimetoprimem – ko-trimoxazol – BISEPTOL… l Bakteriostatická, špatný průnik do tkání Nitrofurantoin (a nifurantel) l Působí na metabolismus cukrů. Je bakteriostatický. Má poměrně široké spektrum l Užívá se na močové infekce. Má však závažné nežádoucí účinky: poruchy GIT aj.

Nitroimidazoly l Působí na syntézu nukleových kyselin u anaerobních bakterií. Kromě nich ale působí také na prvoky (T. vaginalis, E. histolytica) l Používá se metronidazol (KLION, ENTIZOL, EFLORAN) a ornidazol (AVRAZOR, TIBERAL) Další skupiny antibakteriálních látek Stále jsou vyvíjeny nové látky. Např. : l. Linezolid –perspektivní protistafylokokové atb

Ukázky co-tromoxazolu a nitroimidazolů

Rezistence mikrobů na antimikrobiální látky l Primární rezistence: všechny kmeny daného druhu jsou rezistentní. Příklad: betalaktamová atb nepůsobí na mykoplasmata, která vůbec nemají stěnu. l Sekundární rezistence: vznikají necitlivé mutanty, a ty při selekčním tlaku antibiotika začnou převažovat. (Escherichie mohou být citlivé na ampicilin, ale v poslední době výrazně přibývá rezistentních kmenů

Mechanismy rezistence l Mikrob zabrání vniknutí antibiotika do buňky l Mikrob aktivně vypuzuje atb z buňky l Mikrob nabídne antibiotiku falešný receptor l Mikrob enzymaticky štěpí antibiotikum (například betalaktamázy štěpí betalaktamová antibiotika)

Epidemiologicky významné rezistence - 1 l MRSA – methicilin rezistentní stafylokoky. Nevpouštějí do svých buněk oxacilin ani jiné betalaktamy. Mnohé MRSA jsou rezistentní také na další atb (makrolidy, linkosamidy). Citlivé zůstávají glykopeptidy (vankomycin, teikoplanin). l VISA, VRSA - stafylokoky částečně nebo úplně rezistentní i na glykopeptidy l VRE – vankomycin rezistentní enterokoky. Snadno se šíří - enterokoky má spousta lidí ve stolici

Epidemiologicky významné rezistence - 2 l Producenti ESBL (Extended Spectrum Beta Lactamase). G- bakterie (klebsiely, ale i E. coli aj. ) mohou tvořit širokospektré betalaktamázy, kde ani účinek inhibitorů není dostatečný. Účinné bývají jen karbapenemy a někdy některá ne-betalaktamová atb. l MLS rezistence je sdružená rezistence na makrolidy a linkosamidy (a steptograminy), u streptokoků a stafylokoků. U S. aureus zatím naštěstí vzácné.

„Antibiotická politika“, atb střediska l Používání širokospektrých antibiotik představuje selekční tlak – přežívají rezistentní kmeny bakterií l V zemích, kde se antibiotika používají volně, bývají vysoké počty rezistencí na antibiotika l U nás existují „volná antibiotika“, která mohou lékaři předepisovat volně, a „vázaná atb“, jež musí schvalovat antibiotické středisko l Atb střediska bývají zřizována při velkých nemocnicích. Dělají i poradenskou činnost.

Metody zjišťování citlivosti in vitro l Zjišťování citlivosti in vitro = v laboratoři l Nezaručí stoprocentní účinnost léčby l Přesto vhodné u většiny nálezů kultivovatelných patogenních bakterií l V běžných případech kvalitativní testy (citlivý - rezistentní). Nejčastěji difusní diskový test. l U závažných pacientů kvantitativní (zjišťujeme MIC), zpravidla E-testem nebo mikrodilučním testem

Difúzní diskový test l Na MH (nebo jiný) agar se štětičkou plošně naočkuje suspenze baktérie l Pak se nanášejí tzv. antibiotické disky – papírky napuštěné antibiotikem l Atb difunduje (prostupuje) z disku agarem dál l Koncentrace atb klesá se vzdáleností od disku l Pokud mikrob roste až k disku, nebo má jen malou zónu, je rezistentní (necitlivý) l Je-li kolem disku dost velká zóna citlivosti (větší než stanovená hranice), je citlivý.
Difúzní diskový test Foto: archiv MÚ

E-testy l Podobné difúznímu diskovému testu l Místo disku se však použije proužek l V proužku stoupající koncentrace atb od jednoho konce ke druhému. l Zóna není kruhová, ale vejčitá. l Test je kvantitativní l Na papírku je stupnice -> jednoduché odečítání

Mikrodiluční test l Atb je v řadě důlků v plastové destičce, koncentrace postupně klesá l Nejnižší koncentrace, která inhibuje růst, představuje hodnotu MIC l Jedna destička se zpravidla použije pro jeden kmen, např. 12 antibiotik, každé v 8 různých koncentracích Foto: archiv MÚ

Zjišťování faktorů rezistence l Někdy je lépe speciálními metodami zjišťovat přítomnost konkrétních faktorů rezistence, např. betalaktamáz. l Může se jednat o diagnostické proužky (chemický průkaz daného enzymu) nebo testy na jiném principu. Foto: archiv MÚ

Děkuji za pozornost
- Slides: 43